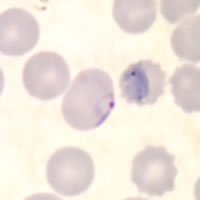
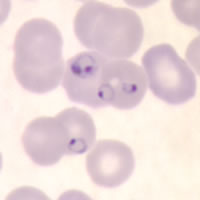
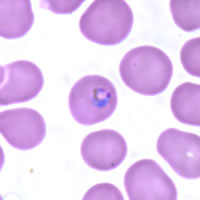

|
Plasmodium
falciparum: Trophozoites
Figs. 11-18:
Increasingly mature trophozoites.
Illustrations from:
Coatney GR, Collins WE, Warren M, Contacos PG. The Primate Malarias. Bethesda: U.S.
Department of Health, Education and Welfare; 1971.
Smears from patients:
Although rarely
seen in peripheral blood smears, older, ring stage parasites are referred
to as trophozoites. The cytoplasm of mature trophozoites tends to be
thicker and more dense than in younger rings. As P. falciparum
trophozoites grow and mature, they tend to retain their ring-like shape
and sometimes trace amounts of yellow pigment can be seen within the
cytoplasm. Growing trophozoites in P. falciparum can appear
slightly amoeboid in shape.
|
|
| A |
B |
A: Appliqué
trophozoite. Note the slight amoeboid appearance of the parasite.
B: A
larger, more mature trophozoite and smaller, younger ring stage parasites
in a thin blood smear.
|
 |
| C |
D |
C, D: More mature and compact trophozoites. Note the presence of
pigment in C.
|